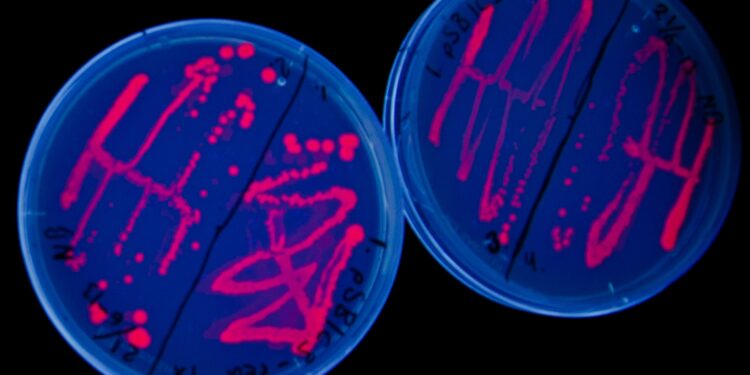

![]()
La biologie synthétique veut créer «de novo» ou «reprogrammer» des organismes dans un but précis. Mais comment l’homme doit-il considérer moralement ces êtres «créés»? La Commission fédérale d’éthique donne son avis
Reconstruire la vie, «biobrique» de cellule par «biobrique», comme on joue aux Lego. Ou – du moins – détourner le fonctionnement originel d’un micro-organisme en le modifiant dans ses entrailles moléculaires pour lui attribuer une fonction inédite. Telle est l’idée de la biologie synthétique, nouveau domaine très prometteur qui associe biochimie, génétique et ingénierie.
Utopie? Musique d’avenir? Les premiers succès sont déjà bien réels. Jay Keasling est parvenu à modifier la machinerie interne de levures pour qu’elles produisent de l’artémisinine, un antipaludéen naturel ardu à générer artificiellement. Pour commercialiser sa découverte, ce chercheur de l’Université de Berkeley a cofondé Amyris. Récemment, cette société s’est lancé un autre défi: «trafiquer» une bactérie pour lui faire produire du biocarburant; la production a commencé en février dans une usine-pilote au Brésil.
Mais l’exemple le plus éclatant est l’expérience menée par Craig Venter. Ce pionnier de la génétique a fabriqué de novo le génome d’une bactérie (M. genitalium), en alignant comme sur un collier, grâce à des machines, des brins d’ADN à partir de quatre perles biologique appelées «bases» (A, C, T et G). Il s’échine maintenant à insérer ce génome artificiel dans une bactérie, et à la faire vivre.
Moult questions se posent autour de ces organismes (re)créés. La Commission fédérale d’éthique dans le domaine non humain (CENH) s’y est penchée dans un rapport, et avise qu’il n’y a pas lieu d’opposer un veto à la biologie synthétique. Le point avec l’un de ses membres, Bernard Baertschi, philosophe à l’Université de Genève.
Le Temps: Le fait que des organismes vivants naissent naturellement ou soient artificiellement générés ou transformés change-t-il leur statut moral, la manière dont l’homme doit se comporter à leur égard?
Bernard Baertschi: L’article 120 de notre Constitution fédérale demande que l’on respecte les organismes vivants lorsqu’ils sont utilisés. On comprend bien l’idée lorsqu’on l’applique à l’être humain. A l’animal aussi. Mais cela s’étend à tout ce qui est vivant. Donc aussi aux micro-organismes comme les bactéries, principaux objets d’étude de la biologie synthétique. On ne peut toutefois pas exclure qu’un jour cette technique soit appliquée aussi à des organismes plus complexes.
Cela dit, la position de la majorité de la CENH, dont je fais partie, est la suivante: qu’un organisme soit fabriqué par un être humain ou par la Nature ne change strictement rien à son statut moral! Il y a deux types d’arguments pour justifier cet avis. Le premier est historico-scientifique: pendant des siècles, on a cru que ce qui distinguait les objets en général était leur caractère naturel ou artificiel. Jusqu’à ce que l’artisan du XVIIe siècle se mette à fabriquer du verre avec du sable. Or la Nature aussi fabrique ce verre dans les cheminées des volcans. Se met donc en place l’idée d’une unité dans le monde naturel – tout est constitué des mêmes atomes –, ceci peu importe l’origine des choses (naturelle ou artificielle). Il en va de même, par exemple, concernant le clonage: imaginons qu’on puisse fabriquer un clone humain. Il s’agirait d’un être humain «produit artificiellement» par un autre homme. Mais tout le monde s’accorderait à dire que le clone aura les mêmes droits et la même valeur qu’un être humain né grâce à la bonne vieille méthode naturelle.
L’autre argument est métaphysique: le statut d’un organisme dépend de ses propriétés intrinsèques, de ce qu’il est en lui-même. Or être généré par la Nature ou par l’homme n’est pas une propriété intrinsèque, mais un mode de production, une propriété dite «relationnelle». Cela n’a donc aucun impact sur le statut moral final.
– La CENH était pourtant divisée. Qu’en pensait la minorité forte?
– Certains membres estiment qu’avec la biologie synthétique, l’on appuie encore plus sur une attitude technicienne, technocrate, envers le vivant. Et que c’est là un bien mauvais rapport que l’homme tisse avec les êtres vivants. On exalterait ainsi le pouvoir de l’homme, on le rendrait tout-puissant, on lui permettrait de «jouer à Dieu», alors qu’il se trouve face à des choses fondamentalement impossibles à maîtriser. A mon avis, si l’on ne maîtrise effectivement pas tout, c’est n’est pas parce que les choses sont par principe non maîtrisables, c’est parce qu’on manque de connaissances.
Un autre point d’opposition au sein de la CENH fut le suivant: d’aucuns pensent que la vie est quelque chose de sui generis, de spécial en soi, de totalement inédit. Et d’autres – dont moi – jugent que la vie est simplement une complexification des organismes élaborée sur une base physico-chimique. Et que ce processus n’est pas moins maîtrisable que n’importe quel autre phénomène physico-chimique; il est seulement plus ardu à saisir.
– L’idée que l’on crée ou transforme ces organismes dans un objectif d’utilité spécifique pour l’homme n’a-t-elle pas pesé dans la balance?
– On peut faire une analogie avec l’élevage: l’homme a aussi adapté à ses propres desseins des êtres vivants. Il en va de même pour les animaux de compagnie… Or là aussi, tout le monde reconnaît le même statut moral à ces animaux, indépendamment de leur utilité.
– Qu’en est-il de la question des risques? L’on se souvient que des journalistes anglais étaient parvenus en 2006 à reconstituer une partie des séquences génétique du virus de la variole, augurant de ce que pourraient imaginer des bioterroristes mal intentionnés…
– Les risques existent, dont certains sont encore inconnus; il ne s’agit plus simplement d’une nouvelle variété de rose ou d’un croisement génétique entre légumes… Pour respecter l’exigence éthique fondamentale qui veut qu’il ne faut pas mettre en danger la vie ou la santé d’autrui sans une très bonne raison, il faut bien étudier ces risques, et appliquer le principe de précaution. Cela passe aussi par des directives, des codes de bonne conduite, établis non pas uniquement par les scientifiques eux-mêmes – comme certains le veulent –, mais aussi par des représentants politiques et de la société. Car, au final, c’est elle qui va être la bénéficiaire ou la victime de cette nouvelle technologie.